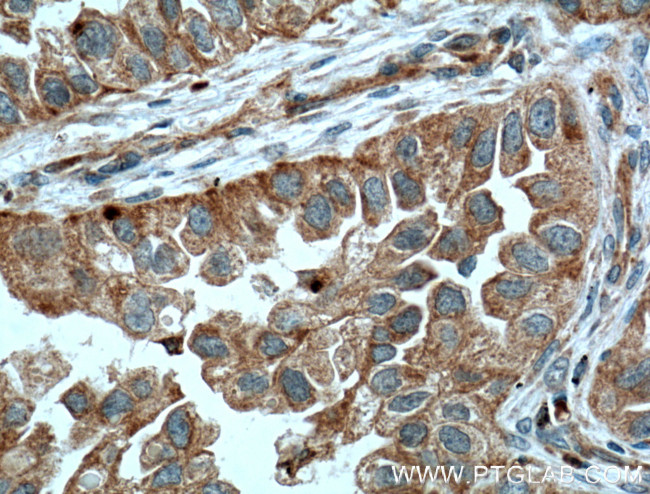
RHOD Antibody in Immunohistochemistry (Paraffin) (IHC (P))

Search
Proteintech
RHOD Polyclonal Antibody
{{$productOrderCtrl.translations['antibody.pdp.commerceCard.promotion.promotions']}}
{{$productOrderCtrl.translations['antibody.pdp.commerceCard.promotion.viewpromo']}}
{{$productOrderCtrl.translations['antibody.pdp.commerceCard.promotion.promocode']}}: {{promo.promoCode}} {{promo.promoTitle}} {{promo.promoDescription}}. {{$productOrderCtrl.translations['antibody.pdp.commerceCard.promotion.learnmore']}}
产品信息
11717-1-AP
种属反应
宿主/亚型
分类
类型
抗原
偶联物
形式
浓度
规格
纯化类型
保存液
内含物
保存条件
运输条件
产品详细信息
Immunogen sequence: MTAAQAAGE EAPPGVRSVK VVLVGDGGCG KTSLLMVFAD GAFPESYTPT VFERYMVNLQ VKGKPVHLHI WDTAGQDDYD RLRPLFYPDA SVLLLCFDVT SPNSFDNIFN RWYPEVNHFC KKVPIIVVGC KTDLRKDKSL VNKLRRNGLE PVTYHRGQEM ARSVGAVAYL ECSARLHDNV HAVFQEAAEV ALSSRGRNFW RRITQGFCVV T (1-210 aa encoded by BC001338)
靶标信息
Blood-group antigens are generally defined as molecules formed by sequential addition of saccharides to the carbohydrate side chains of lipids and proteins detected on erythrocytes and certain epithelial cells. The A, B and H antigens are reported to undergo modulation during malignant cellular transformation. Blood group related antigens represent a group of carbohydrate determinants carried on both glycolipids and glycoproteins. They are usually mucin-type, and are detected on erythrocytes, certain epithelial cells, and in secretions of certain individuals. Sixteen genetically and biosynthetically distinct but inter-related specificities belong to this group of antigens, including A, B, H, Lewis A, Lewis B, Lewis X, Lewis Y, and precursor type 1 chain antigens.
仅用于科研。不用于诊断过程。未经明确授权不得转售。
篇参考文献 (0)
生物信息学
蛋白别名: ras homolog D; ras homolog gene family, member A; ras homolog gene family, member D; Rh(o); Rh(o)ii; Rho-related GTP-binding protein RhoD; Rho-related protein HP1; RhoHP1; small GTP binding protein
基因别名: ARHD; Rho; RHOD; RHOHP1; RHOM
UniProt ID: (Human) O00212
Entrez Gene ID: (Human) 29984